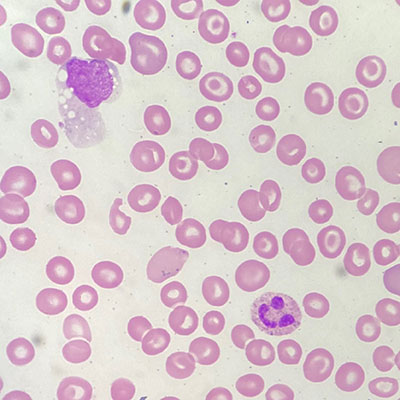
Koriann Tiesi

Beginning in Fall 2025, the Doctoral Hooding Ceremony will serve as the official commencement ceremony honoring the achievements of UAB’s PhD, DSc, DrPH, and EdD candidates. This ceremony will be held in the spring and fall semesters. All students planning to complete their studies at the end of the summer semester can choose to participate in either the spring or fall hooding ceremony.
Fall 2026 Doctoral Hooding Ceremony:
Wednesday, December 9
6:00 p.m.
Alys Stephens Performing Arts Center
1200 10th Ave S, Birmingham, AL 35294
This special ceremony – a commencement event designed exclusively for our doctoral graduates who submit a Plan 1 dissertation – is a more intimate gathering than the general commencement ceremonies for other students.
We look forward to honoring your accomplishments in a ceremony that is personal, celebratory, and academically focused. This event will highlight the significance of the truly unique and unparalleled scholarly journey you’ve completed.
A brief reception will follow the ceremony.
Please RSVP by November 12, 2026.
By submitting an RSVP for the Doctoral Hooding Ceremony, you are also registering to walk during this ceremony.
If you plan to attend the Doctoral Hooding Ceremony, you must complete this RSVP in order to walk, in addition to submitting your degree application.
Candidates who do not RSVP by the deadline will not be permitted to participate in the ceremony. Submitting your RSVP ensures we can include you in seating and event planning. If you are unsure whether you will attend, we encourage you to RSVP anyway–it is much easier for us to plan for extra seating than to accommodate unregistered participants.
Apply for Degree & Purchase Regalia
-
Apply for Degree
Apply for Degree
The deadline to apply for your degree is June 8, 2026. Please follow the steps below to apply for your degree/certificate:
- Login to BlazerNET,
- Select the Links/Forms tab,
- Under Forms select Apply for Graduate Degree/Certificate,
- Follow the prompts and submit,
- You will receive a confirmation email that your application is under review and a fee will be assessed to your student account ($20-certificates, $60-master’s and doctoral degrees).
If you have submitted your application, it will state your application is pending and there will be an error message. It takes time for the application to process so do not panic if your application is pending for a while. If you have any questions or concerns with your AFD/ AFC, please email Lily Leath.
If you do not complete your degree requirements by your expected graduation date, you will need to update your graduation term. Please do not submit a new Application for Degree. Instead, complete the Change of Graduation Date form in Blazernet.
-
Regalia & Merchandise
Regalia & Merchandise
More information regarding regalia and additional merchandise can be found online through the UAB Commencement webpage.
The deadlines to purchase/ rent regalia are as follows:
- Doctoral regalia rental: October 20
- Custom doctoral regalia purchase: October 4
Venue Info and Policies
The Graduate School Doctoral Hooding Ceremony will be held at the Alys Stephens Center (ASC).
-
Parking and Directions
Parking and Directions
For directions and parking maps, please visit alysstephens.org/visit/parking-directions/.
-
Accessibility
Accessibility
To see UAB’s Policy on accommodations and accessibility, please visit alysstephens.org/visit/accessibility/.
-
Late Seating Policy
Late Seating Policy
Depending on the time of the hooding ceremony, late arrivals are a distraction to the graduates and other attendees. Patrons who arrive late will be seated by an usher at an appropriate time during the ceremony. Please be aware that this may result in missing a portion of the hooding ceremony.
Please plan to arrive at least 30 minutes prior to the beginning of the hooding ceremony.
-
Smoking and Tobacco Use
Smoking and Tobacco Use
Use of tobacco or smoking-related products is prohibited within all buildings, facilities, vehicles, and spaces (including covered walkways, covered parking, parking lots, commons, parks, and campus greens) that are owned, rented, leased, or otherwise controlled by the UAB and otherwise in accordance with city ordinance. UAB may specifically designate in writing appropriate outdoor areas (if any) that have been approved to accommodate use of tobacco or smoking-related products. Signage will indicate limited areas where such use is acceptable. Littering the campus or surroundings with remnants of tobacco or smoking-related products is also prohibited. Individuals who choose to use tobacco or smoking-related products in designated areas are expected to place remains in proper receptacles.
For more information on the UAB Non-Smoking Policy, please visit uab.edu/policies/content/Pages/UAB-HS-POL-0000110.html.
-
Backpack and Large Bags
Backpack and Large Bags
Backpacks and large bags are not permitted in the performance halls. Please leave them in your vehicle. The ASC cannot be held responsible for any damage that may occur outside of the venues.
Frequently Asked Questions
-
What are the eligibility requirements for the Doctoral Hooding Ceremony?
What are the eligibility requirements for the Doctoral Hooding Ceremony?
Students may take part in one commencement ceremony and typically participate in the ceremony held at the end of the semester in which they complete their degree requirements. The Doctoral Hooding Ceremony will be held in the spring and fall semesters. All students planning to complete their studies at the end of the summer semester can choose to participate in either the spring or fall hooding ceremony.
In certain extenuating circumstances, and with official university approval, students may be permitted to participate in a ceremony up to eight months before or after their official completion date.
-
Where will the ceremony be held?
Where will the ceremony be held?
The Graduate School Doctoral Hooding Ceremony will be held at the Alys Stephens Center.
-
When will the ceremony be held?
When will the ceremony be held?
Wednesday, December 9 at 6:00pm – doors open at 5:00pm.
-
Where should we park?
Where should we park?
For directions and parking maps, please visit alysstephens.org/visit/parking-directions/.
-
How many guests can we bring?
How many guests can we bring?
There is no limit on family, friends, and guests.
-
Are there any clothing or bag restrictions?
Are there any clothing or bag restrictions?
Backpacks and large bags are not permitted in the ASC performance halls. Please leave them in your vehicle. The ASC cannot be held responsible for any damage that may occur outside of the venues.
There is no strict clothing restrictions, however we do ask that all guests please dress business casual.
-
Will there be a reception?
Will there be a reception?
Light refreshments will follow the ceremony.
-
How long will the ceremony last?
How long will the ceremony last?
The ceremony will last around one hour.
-
When should we arrive?
When should we arrive?
Graduates need to arrive 60 minutes prior to the ceremony start time. Guests may begin arriving at least 30 minutes prior to the ceremony.
-
How do we get to our designated areas?
How do we get to our designated areas?
Once you enter the Alys Stephens Center, graduates will be directed to our meeting location where we will prep you for the ceremony and ensure you have your dissertation card.
There will be no reserved areas for guests. Seating is available on a first-come basis.
-
How should we prepare for the ceremony once we arrive?
How should we prepare for the ceremony once we arrive?
Graduates will be directed to our meeting location where we will demonstrate the hooding process and help prepare you for the hooding ceremony.
-
Will there be a traditional handshake and photo?
Will there be a traditional handshake and photo?
Yes, the Graduate School will have a photographer available that will take your photo of you and your mentor when you are hooded.
-
Will the ceremony be livestreamed?
Will the ceremony be livestreamed?
Yes, we will livestream on our YouTube channel.
-
How will I receive updates about any changes to the ceremonies?
How will I receive updates about any changes to the ceremonies?
You will always receive an email from the UAB Graduate School account.
-
How soon after the ceremony will I receive my diploma?
How soon after the ceremony will I receive my diploma?
Assuming you have no financial holds on your student account, you will receive your diploma in the mail, to the address on file in Blazernet, within 6-8 weeks after final grades are posted.
-
When will I receive photos taken at commencement?
When will I receive photos taken at commencement?
A link to a box folder containing photos from the ceremony and reception will be emailed to your UAB email around 1-2 weeks after the ceremony.
-
What if I have questions about regalia?
What if I have questions about regalia?
Please direct all questions regarding regalia (cap and gown) to the UAB Bookstore: sm536@bncollege.com or (205) 996-2665.
-
What are dissertation cards?
What are dissertation cards?
Dissertation cards are what you will present to the speaker before you cross the stage to be hooded, and will contain your name, dissertation title and hooding mentor/ chair.
You will receive emails prior to the ceremony with details to pick yours up. It is imperative that you pick yours up prior to the ceremony to ensure that all of your information is displayed correctly.
-
I am completing more than one degree, will my degrees be announced at the ceremony?
I am completing more than one degree, will my degrees be announced at the ceremony?
No, only your doctoral degree will be honored at this ceremony. If you are completing a master’s degree or certificate in the semester you have applied for your degree, then both your honors will be featured in the commencement book for that semester.
Graduates may not attend more than one hooding ceremony.
-
Where do I learn more about accessibility accommodations?
Where do I learn more about accessibility accommodations?
To see UAB’s Policy on accommodations and accessibility, please visit alysstephens.org/visit/accessibility/.
Contacts for Additional Questions
Diploma questions should be directed to the Registrar's Office: registrar@uab.edu or 205-934-8228
Regalia questions should be directed to the UAB Bookstore: sm536@bncollege.com or 205- 996-2665
Graduate school questions should be directed to the Graduate School: gradschool@uab.edu or 205-934-8227
Graduate School Awards Ceremony
The UAB Graduate School Awards Ceremony is an annual celebration recognizing the exceptional achievements, service, and impact of members of our graduate community. This event honors outstanding graduate students, faculty and staff whose contributions support the success and collaborative spirit of our graduate community.
Date and time:
- Wednesday, April 15, 2026
- 4:00pm
Location:
- UAB National Alumni Society
- 1301 10th Ave S, Birmingham, AL 35294
Awards Recognized
The ceremony includes recognition of recipients across several award categories, which include:
- Samuel B. Barker Award
- Dean’s Excellence in Mentorship Award
- Inaugural Graduate School Program Admin Award
- Graduate School Staff Award
- Three Minute Thesis Winner
- GBS Faculty Service Award
- GBS Faculty Engagement Award
- GBS Faculty Teaching Award
- GBS Student Service Award
- GBS Student Engagement Award
- GBS Student Mentorship Award
The UAB Graduate School Awards Ceremony reflects our shared commitment to recognizing the people who make UAB exceptional. For questions about the ceremony or awards process, please contact Nathan Anderson.
Graduate School Fair
Representatives from a wide range of UAB graduate programs will participate in the UAB Graduate School Fair, offering prospective and current students the opportunity to explore advanced degree and certificate options across disciplines. The fair will feature programs from across campus, including STEM, health professions, business, education, arts, and humanities.
Date and time:
- Thursday, July 9, 2026
- 11:00am - 2:00pm
Location:
- UAB Hill Student Center, Third Floor Ballrooms
- 1400 University Blvd, Birmingham, AL 35294
The Graduate School Fair is a convenient, one-stop opportunity to connect directly with program representatives, ask questions about graduate curricula, admissions requirements, research opportunities, and career pathways, and learn more about funding options, professional development, and student support services.
To make the most of your time at the fair, we encourage attendees to review the list of participating programs in advance and plan which tables they would like to visit. This preparation will help ensure meaningful, one-on-one conversations with representatives and allow you to gather the information you need to take the next step in your graduate education.
Participating Programs:
-
Graduate School
Graduate School
- Accelerated Learning Programs
- Graduate Biomedical Sciences: PhD
- Interdisciplinary Graduate & Professional Studies: Graduate Certificate
- Interdisciplinary Graduate Studies: combine two graduate certificates into one interdisciplinary degree
- Multidisciplinary Biomedical Sciences: MBS
-
Collat School of Business
Collat School of Business
• Accounting: MAc
• Business Administration: MBA; MBA/ DMD; MBA/ MEng; MBA/ MSHA; MBA/ MD; MBA/ OD; MSN /MBA; MPH/ MBA
• Business Analytics with Information Technology: Graduate Certificate
• Cybersecurity Management: Graduate Certificate
• Digital Marketing: Graduate Certificate
• Foundations of Business Administration: Graduate Certificate
• Management Information Systems: MS
• Technology Commercialization and Entrepreneurship: Graduate Certificate -
College of Arts and Sciences
College of Arts and Sciences
- Anthropology of Peace and Human Rights: MA
- Applied Mathematics: PhD
- Artifical Inteligence: MS
- Biology: MS, PhD
- Computer Science: MS, Graduate Certificate
- Criminal Justice: MS
- Cybersecurity: MS
- Digital Forensics: Graduate Certificate
- English: MA
- Forensic Science: MS
- Mathematics: MS
- Medical Sociology: PhD
- Nonprofit Management: Graduate Certificate
- Public Administration: MPA
- Public Management: Graduate Certificate
- Sociology: MA
-
School of Education and Human Sciences
School of Education and Human Sciences
- Education: EdS
- Learning Design & Learning Sciences: MS, Graduate Certificate
- Higher Education: MS
- Higher Education Administration: MS, Graduate Certificate
- Physical Education: Graduate Certificate
- Special Education: MAEd, Graduate Certificate
- Secondary Education: MAEd
-
School of Health Professions
School of Health Professions
- Biomedical and Health Sciences: MS
- Biotechnology: MS
- Clinical Laboratory Sciences: MS
- Genetic Counseling: MS
- Health Administration Executive: MS
- Health Administration Residential: MS
- Health Informatics: MS
- Health Physics: MS
- Healthcare Quality and Safety: MS
- Healthcare Simulation: MS
- Medical Laboratory Science: MS
- Nuclear Medicine and Molecular Imaging Sciences: MS
- Nutrition Sciences, Clinical Track Dietetic Internship: MS
- Nutrition Sciences, Clinical Track Prior Learning, MS
- Nutrition Sciences, Dietitian Education Program MS
- Nutrition Sciences, Lifestyle Management and Disease Prevention: MS
- Nutrition Sciences, Research Track: MS
- Occupational Therapy: MS
- Physician Associate Studies: MS
- Administration Health Services, PhD
- Biotechnology: PhD
- Healthcare Leadership: DsC
- Nutrition Sciences: PhD
- Occupational Therapy Doctorate (Entry-Level)
- Occupational Therapy Doctorate (Post-Professional)
- Doctor of Physical Therapy
- Rehabilitation Science: PhD
- Graduate Certificate in Applications of Mixed Methods Research
- Graduate Certificate in Biotechnology Regulatory Affairs
- Graduate Certificate in Clinical Informatics
- Graduate Certificate in Dietitian Education (DEP-C)
- Graduate Certificate in Healthcare Leadership
- Graduate Certificate in Healthcare Quality and Safety
- Graduate Certificate in Healthcare Simulation
- Graduate Certificate in Industry Genetics and Genomics
- Graduate Certificate in Low Vision Rehabilitation
- Graduate Certificate in Nutrition for Community Health
- Graduate Certificate in Primary Care Physical Therapy for Underserved Populations
-
Heersink School of Medicine
Heersink School of Medicine
- Anatomical Science: MS
- AI in Medicine: MS, Graduate Certificate
- Global Health: MS
- Healthcare Innovation: MS, Graduate Certificate
- Medical Scientist Training Program: MD/ PhD
- Marnix E. Heersink Institute for Biomedical Innovation
-
School of Public Health
School of Public Health
- Biostatistics: MS, MSPH, DrPH, PhD, Graduate Certificate
- Climate and Health: Graduate Certificate
- Disability Health Studies: Graduate Certificate
- Environmental Health and Safety: MPH, MSPH, PhD, Graduate Certificate
- Epidemiology: MPH, MSPH, PhD
- Health Behavior: MPH, PhD, Graduate Certificate
- Health Policy and Organization: MPH/MSPH, MSPH IHY, DrPH, Graduate Certificate
- LGBTQ Health and Wellbeing: Graduate Certificate
- Population Health & Coordinated Degree Programs: MPH
- Public Health in Outcomes Research: MS
-
School of Optometry
School of Optometry
• Optometry: OD, OD/MS, OD/ MPH, OD/ MBA
• Vision Science: MS, OD/MS, PhD -
School of Dentistry
School of Dentistry
- DMD/PhD Program
People's Choice voting is now open for UAB Graduate School's Say it in 6 for 2023.
Student Division
Faculty/Staff Division
-
Global Engagement
Leadership
Love
Persistence
Social Justice
-
Global Engagement
Leadership
Love
Persistence
Social Justice
Graduate Student Appreciation Week
Each year, the UAB Graduate School is proud to celebrate the many contributions our graduate students’ make to our university and community. During this week, the Graduate School in partnership with the Graduate Student Government (GSG), and other campus partners, create a series of events to recognize and show appreciation for our extraordinary students!
Check out what all is happening this week below:
-
Monday: Opening Bash
Monday: Opening Bash
Celebrate the start of Graduate Student Appreciation Week at the Opening Bash on the Campus Green! Enjoy food trucks, games, music from a live DJ, and campus organizations tabling while connecting with fellow graduate students and kicking off a week of appreciation.
Date: Monday, March 30, 2026
Time: 4:00 p.m. - 6:00 p.m.
Location: Campus Green
-
Tuesday: Grad Grab and Go
Tuesday: Grad Grab and Go
Need a quick pick-me-up? Visit one of our Grad Grab and Go locations across campus to grab a free snack bag and keep your day moving during Graduate Student Appreciation Week!
Date: Tuesday, March 31, 2026
Time: 11:00 a.m. - 1:00 p.m.
Locations: Shelby Building, patio | Lister Hill Library, patio | Heritage Hall, entrance
-
Tuesday: Jackbox Game Night
Tuesday: Jackbox Game Night
Unwind during Graduate Student Appreciation Week with a virtual Jackbox Game Night on Zoom. Graduate students are invited to connect, play interactive party games, and enjoy a fun evening of laughter and friendly competition.
Date: Tuesday, March 31, 2026
Time: 4:00 p.m. - 6:00 p.m.
Location: Zoom | Click here to join.
-
Wednesday: Pizza, Paws and Pause
Wednesday: Pizza, Paws and Pause
Grab a slice and take a well-deserved break at Pizza, Paws and Pause! Enjoy pizza, connect with campus organizations, and relax with therapy dogs visiting from Hand in Paw.
Date: Wednesday, April 1, 2026
Time: 12:00 p.m. - 2:00 p.m.
Location: Lister Hill Library, patio
-
Thursday: Game and Trivia Night
Thursday: Game and Trivia Night
Level up your night at Game and Trivia Night at Up-Down Arcade Bar! Test your knowledge during trivia, enjoy classic arcade games, and connect with fellow graduate students. Free game tokens and food vouchers will be available for attendees while supplies last.
Date: Thursday, April 2, 2026
Time: 4:00 p.m. - 7:30 p.m.
Location: Up Down Arcade Bar
-
Friday: Grad Vendor Village
Friday: Grad Vendor Village
Visit the Grad Vendor Village during Graduate Student Appreciation Week to connect with local vendors and pick up fresh produce provided by Live HealthSmart Alabama. Graduate students can explore a variety of vendors while supporting healthy living and community engagement.
Date: Friday, April 3, 2026
Time: 11:30 p.m. - 3:30 p.m.
Location: Altec/Styslinger Genomic Medicine & Data Sciences, terrace and patio